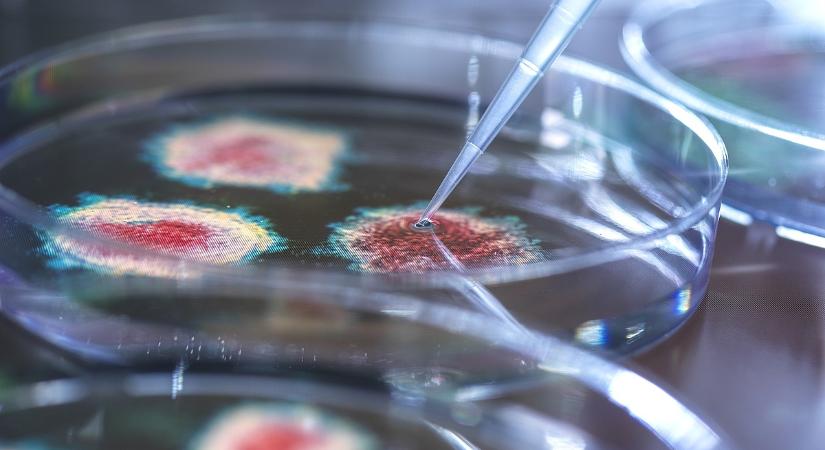
Nem véd az oltás, nincs gyógyszer: a következő sokk nem onnan jön, ahonnan várjuk

Nem véd az oltás, nincs gyógyszer: a következő sokk nem onnan jön, ahonnan várjuk
Egy amerikai fertőző betegségekkel foglalkozó kutató szerint nem azok a vírusok jelentik a legnagyobb veszélyt 2026-ban, amelyekről a legtöbbet beszélnek. Három kórokozó hordozhat komolyabb ... ...
- Hirdetés -